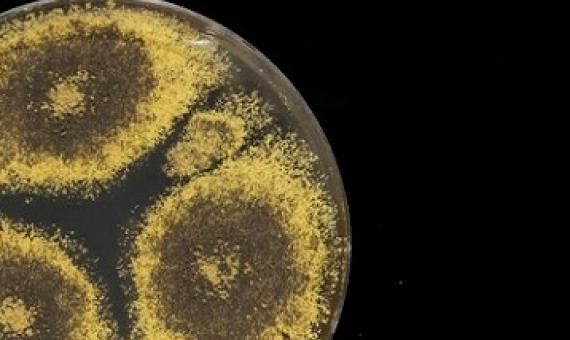
A culture of Eurotium herbariorum fungus, often retrieved from ocean-floor sediments.Credit: Tom Kleindinst/Woods Hole Oceanographic Institution (WHOI)

People gathered in the thousands in Mauritius’s capital, Port Louis, to protest the government’s response to a recent oil spill. The Japanese-owned freighter M.V.
When the cargo ship MV Wakashio ran aground on a coral reef on the southeast tip of Mauritius, in the Indian Ocean almost exactly a month ago, it unleashed a vast oil spill.
At least 38 dead dolphins have washed ashore on the island of Mauritius in the aftermath of a massive oil spill from a Japanese ship.
Environmental groups on Thursday said almost all the remaining oil has been pumped from the Japanese ship that struck a coral reef off the south-east coast of Mauritius in late July, limiting further damage from an oil spill that has likely caused “irreversible” ecological blows...“Make no mistak
In the Maldives, a developing nation that lacks much local manufacturing, a single tourist produces almost twice as much trash per day as a resident of the capital city of Malé, and five times as much as residents of the other 200 populated islands, according to government statistics.
Australia's Flinders University, on August 1, declared Maldives to be one of the countries most polluted by microplastics, on the planet. Microplastics refer to plastic particles measuring less than five millimetres and are now globally recognized as a pollutant of increasing concern.
A ship that ran aground on a coral reef has leaked about 900 tons of fuel oil into the waters off the southeastern coast of Mauritius. The incident occurred on July 25, and by Aug.
At the bottom of the Indian Ocean, in one of the deepest layers of Earth’s crust ever explored, researchers are finding life.




![This aerial view taken on August 8, 2020 shows a large patch of leaked oil and the vessel MV ... [+] AFP VIA GETTY IMAGES](/sites/default/files/styles/news_teaser/public/Mauritius_OILspill.jpg?itok=4dYNhfvd)